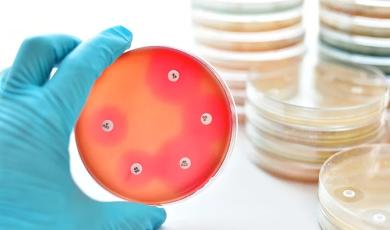
Join Us in Raising Awareness about Antimicrobial Stewardship

Our Blog
We believe that knowledge is power, and our mission is to empower scientists, researchers, and healthcare professionals with the tools they need to make breakthrough discoveries and deliver the best possible care to patients.
Our blog offers a platform for in-depth articles, expert perspectives, and real-world applications, all aimed at showcasing the incredible impact of our work on a global scale.

Faces of Luminex
Febbraio 23, 2024The Faces of Luminex: Rachel Badillo, LuminexPLORE Lab
Discover more
Faces of Luminex
Febbraio 16, 2024The Faces of Luminex: Bruno De Oliveira, Engineering
Discover more
Faces of Luminex
Gennaio 22, 2024The Faces of Luminex: Carrie Wittmer, LuminexPLORE Lab
Discover more
xMAP® Multiplexing
AAPS PharmSci 360 2023: Making Strides to Tackle Complexity in Drug Development
Discover more
xMAP® Connect | xMAP® Multiplexing
Dicembre 14, 2023At xMAP® Connect Atlanta, Customers Highlighted the Benefits of Multiplexing Across Multiple Applications
Discover more
xMAP® Multiplexing
Don’t Miss the Latest Issue of xMAP® Insights Magazine
Discover more
Molecular Testing
Novembre 22, 2023Join Us in Raising Awareness about Antimicrobial Stewardship
Discover morePaginazione
- Prima pagina
- …
- 2
- 3
- 4
- 5
- 6
- 7
- 8
- 9
- 10
- …
- Ultima pagina

